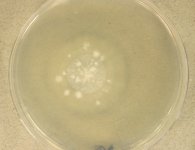

Search Details
| UAMH Number: | 10961 |
|---|---|
| Species Name: | Aspergillus chlamydosporus |
| Type: | Sagenomella chlamydospora |
| Synonyms: | Phialosimplex chlamydosporus / Sagenomella chlamydospora |
| Taxonomy: | FUNGI Ascomycota, Eurotiomycetes, Eurotiales, Aspergillaceae |
| Strain History: | M.E. Garcia -> CBS 109945 -> UAMH |
| Substrate: | disseminated infection in a dog (German shepherd cross) isolated post-mortem from many organs including kidneys, mitral valve, abdominal aorta and vertebral discs; histopathology + for hyphae | Location: | SPAIN Madrid, Veterinary School of Madrid (GEO: 40.45,-3.739) |
| Isolator: | M.E. Garcia |
| Isolation Date: | 2000 |
| Date Received: | 2008-12-05 |
| Characters: | CYCLOHEXIMIDE sensitive (MYC) - // HUMAN/ ANIMAL PATHOGEN disseminated infection in a dog - Garcia ME, Caballero J, Toni I, Garcia E, Martínez de Merlo E, Rollan E, González M, Blanco JL. 2000, J Vet Med A 47:243-249, 2000 // HUMAN/ ANIMAL PATHOGEN disseminated infection in a dog - Gene J, Blanco JL, Cano J, García ME, Guarro J, J Clin Microbiol 41:1722-1725, 2003 // MOLECULAR SYSTEMATICS Phialosimplex new genus within the Trichocomaceae - Sigler L, Sutton DA, Gibas CF, Summerbell RC, Noel RK, Iwen PC, Med Mycol 48:335-345, 2010 // THERMOTOLERANT growth equivalent at 30 & 35C - (Click for publications citing UAMH 10961) |
| Compounds: | |
| Cross Reference: | CBS 109945 // IMI 387422 |
| Collections: | Living Strains; Dried Herbarium Material |
| Pathogenic Potential: | Human: yes | Animal: yes | Plant: no |
| Biosafety Risk Group: | RG2 (check the PHAC ePATHogen Risk Group Database for updates) |
| Regulatory Requirements: | Canadian requesters must provide PHAC Pathogen and Toxin License Number (see: https://www.canada.ca/en/public-health/services/laboratory-biosafety-biosecurity/licensing-program.html) and a CFIA Written Authorization for transfer (http://www.inspection.gc.ca/plants/plant-pests-invasive-species/directives/date/d-12-03/eng/1432656209220/1432751554580#app2) prior to shipment. International requesters must provide all legally required importation documentation prior to shipment. Plant pathogenicity status may be verified by using the USDA Agricultural Research Service (ARS) Fungal Database |
| MycoBank ID: | 809584 |
| Sequences: | >UAMH10961_UAMH_BT2 GGTACGTCCCGACCACGATAACAGGACAGGACAATGGAACATGGATTCTGAATGCCCTGGATGTCGAATGCTGCTTGCTAACCAGTCTATAGGCAGACCATCGCTGGCGAGCATGGCCTGGACGGCGCCGGCGTGTAAGTGAAAGCCGCGCGTTTTGTTGTTGTTTCGGATACATCCGAGAGATGGATCGAAGCCTGACATAGACCAGGTACAATGGCTCCTCCGATCTCCAGCTGGAGCGTATGAACGTCTACTTCAACGAGGTTTGTGCTTGGCCCTGGATTTAATTGATCTAATGCTTGCGTGTGTTGACTACTATCCAGGCTAGCGGAAACAAGTATGTCCCTCGTGCCGTTCTGGTCGACCTTGAGCCCGGTACCATGGATGCCGTCCGTGCAGGTCCCTTTGGCCAGCTCTTCCGTCCCGACAACTTTGTTTTCGGCCAGTCTGGCGCTGGTAACAACTG >UAMH10961_JN121879_Cct8 GCCCAGAAGGCCAAAGTTGGCGTGTTTAGCTGCCCGATCGACATCTCTCAGACCGAGACCAAGGGAACCGTTCTGCTAAAGAACGCGCAGGAGATGCTTGACTATACCAAGGGCGAGGAGGACCGTCTCGAGACGGCTGTTAAGGAGCTCTACGACTCGGGCATCCGCGTCGTTGTTGCTGGCGCCACTGTTGGCGACTTGGCCCTCCACTACCTCAATCGCTTCAATATCCTCGTCATCAAGATCCAGTCGAAGTTTGAGCTCCGTCGGCTCTGTCGCGTCGTTGGTGCTACTCCTCTCGCCCGCTTGGGCGCTCCGATGCCCGACGAGATGGGCAGCGTCGATGTCGTTGAAACCACGGAAATTGGTGGTGACCGAGTCACCGTCTTCCGGCAAGAAGATCCCAGCGCAGTGACTCGCACAGCGACCATTGTCCTACGCGGAGCCACCCAGAACCATCTGGATGACGTCGAGCGTGCCATCGATGACGGTGTCAATGCTATCAAGGCTATCACGAAGGATCCGCGCCTCGTCCCCGGTGCGGGAGCTACCGAGATCCAGCTTGTAGAGAGAATCTCCGCGTTTGCCGACAGGACCCCCGGATTGCCCCAACATGCTATCCGGAAGTTTGCCGAAGCATTCGAGGTGATTCCGCGCACTCTCGCAGAGTCTGCCGGCTTGGATGCCACGGAGGTTCTTTCTCGCCTCTACACT >UAMH10961_AJ519984_ITS TATCGAGTGCGGACCCTCCGGGGTGCCAACCTCCCACCCGTGTCTACCGTACCACGTTGCTTCGGCGGGCCCGCCCCCCTCAGCAAGGGGGGGGCCGTCGGGGGGCATCTGCCCCCGGGCGTGTGCCCGCCGGAGACCCCCACACGAACACTGTCTGAAGGACTGCTGTCTGAGTGGATTGATCAAATCAGTTAAAACTTTCAACAACGGATCTCTTGGTTCCGGCATCGATGAAGAACGCAGCGAACTGCGATAAGTAGTGTGAATTGCAGAATTCAGTGAATCATCGAGTCTTTGAACGCACATTGCGCCCCCTGGCATTCCGGGGGGCATTCCTGTCCGAGCGTCATTGCTACCCTCAAGCACGGCTTGCGTGTTGGGCCGCCGTCCGCCCCGCTCCAGGGGGGGACGGGCCCGAAAGGCAGCGGCGGCACCGCGTCCGGTCCTCGAGCGTATGGGGCTCTGTCACCCGCTCCGTGGGGTCGGCCGGCGCTAGCCTGGGCAACCATCTTCTTTTACCAGGTT >UAMH10961_UAMH_ITS TCATTACCGAGTGCGGCACCCTCCGGGGTGCCAACCTCCCACCCGTGTCTACCGTACCACGTTGCTTCGGCGGGCCCGCCCCCCTCAGCAAGGGGGGGGCCGTCGGGGGGCATCTGCCCCCGGGCGTGTGCCCGCCGGAGACCCCCACACGAACACTGTCTGAAGGACTGCTGTCTGAGTGGATTGATCAAATCAGTTAAAACTTTCAACAACGGATCTCTTGGTTCCGGCATCGATGAAGAACGCAGCGAACTGCGATAAGTAGTGTGAATTGCAGAATTCAGTGAATCATCGAGTCTTTGAACGCACATTGCGCCCCCTGGCATTCCGGGGGGCATGCCTGTCCGAGCGTCATTGCTACCCTCAAGCACGGCTTGCGTGTTGGGCCGCCGTCCGCCCCGCTCCAGGGGGGGACGGGCCCGAAAGGCAGCGGCGGCACCGCGTCCGGTCCTCGAGCGTATGGGGCTCTGTCACCCGCTCCGTGGGGTCGGCCGGCGCTAGCCTGGGCAACCATCTTCTTTTTACCAGGTTGACCTCGGATCAGG >UAMH10961_JN121566_RNApol2 GTGTCTCCCCAGCGCAATGGTCCGCTCATGGGTATTGTGCAAGATACACTTTGCGGTATCTATAAGATTTGTCGGCGCGATACATACCTAACCAGGGAACAAGTGATGAATATCATGCTTTGGGTTCCAGACTGGGATGGTGTTATTCCTCCTCCGGCTATCGTGAAGCCTCGACCCAGATGGACCGGAAAACAGATGATCAGCATGGCTCTTCCATCTGGCCTCAATTTGCTCCGGGTCGATAAAGACAGCTCGACTCTTGCTGAGAAGTTCTCTCCCATCAATGACGATGGCTTGCTTATCCACGGTGGACAGTTGATGTATGGGATGTTCTCCAAGAAAACTGTTGGTGCCAGTGGTGGTGGTGTCATCCATATCATTTTCAATGAATATGGAGTAGATGCTGCCGTCGCTTTCTTCAACGGTGCTCAGACCATTGTCAACTATTGGCTACTACACAATGGCTTCAGTATCGGGATTGGTGATACGATCCCAGATCCTTTAACAATTCAGAGAATTGAGGACTGCGTTCGCAATCGCAAGAAGGAGGTTGAAGCCATTACGCAAAGCGCAACGGATAATACTCTCGAGCCGCTTCCCGGTATGAATGTGCGAGAGACCTTTGAGAGCAAGGTAGCGCGTGCGCTTAATAACGCACGTGATGAAGCCGGTGGTGAAACTGAGAAGAGTTTGAGGGATAGTAACCATGCTATCCAAATGGCTCGTTCTGGATCAAAGGGTTCTACTATCAACATTTCCCAGATG >UAMH10961_GQ169326_SSU-LSU TAAGCCATGCATGTCTAAGTATAAGCACTTTATACGGTGAAACTGCGAATGGCTCATTAAATCAGTTATCGTTTATTTGATAGTGCCTTACTACATGGATACCTGTGGTAATTCTAGAGCTAATACATGCTGAAAACCCCGACTTCGGAAGGGGTGTATTTATTAGATAAAAAACCAACGCCCTTCGGGGCTCCTTGGTGATTCATGATAACTTAACGAATCGCATGGCCTTGCGCCGGCGATGGTTCATTCAAATTTCTGCCCTATCAACTTTCGATGGTAGGATAGTGGCCTACCATGGTGGCAACGGGTAACGGGGAATTAGGGTTCGATTCCGGAGAGGGAGCCTGAGAAACGGCTACCACATCCAAGGAAGGCAGCAGGCGCGCAAATTACCCAATCCCGACACGGGGAGGTAGTGACAATAAATACTGATACGGGGCTCTTTTGGGTCTCGTAATTGGAATGAGAGCAATTTAAACCCCTCATCGAGGAACAATTGGAGGGCAAGTCTGGTGCCAGCAGCCGCGGTAATTCCAGCTCCAATAGCGTATATTAAAGTTGTTGCAGTTAAAAAGCTCGTAGTTGAACCTTGGGCCTGGCTGGCCGGTCCGCCTCACCGCGAGTACTGGTCCGGCTGGGCCTTTCCTTCTGGGGAACCCCATGGCCTTCACTGGCTGTGGGGGGAACCAGGACTTTTACTGTGAAAAAATTAGAGTGTTCAAAGCAGGCCTTTGCTCGAATACATTAGCATGGAATAATAGAATAGGACGTGCGGTTCTATTTTGTTGGTTTCTAGGACCGCCGTAATGATTAATAGGGATAGTCGGGGGCGTCAGTATTCAGCTGTCAGAGGTGAAATTCTTGGATTTGCTGAAGACTAACTACTGCGAAAGCATTCGCCAAGGATGTTTTCATTAATCAGGGAACGAAAGTTAGGGGATCGAAGACGATCAGATACCGTCGTAGTCTTAACCATAAACTATGCCGACTAGGGATCGGACGGTGTTTCTATGATGACCCGTTCGGCACCTTACGAGAAATCAAAGTTTTTGGGTTCTGGGGGGAGTATGGTCGCAAGGCTGAAACTTAAAGAAATTGACGGAAGGGCACCACAAGGCGTGGAGCCTGCGGCTTAATTTGACTCAACACGGGGAAACTCACCAGGTCCAGACAAAATAAGGATTGACAGATTGAGAGCTCTTTCTTGATCTTTTGGATGGTGGTGCATGGCCGTTCTTAGTTGGTGGAGTGATTTGTCTGCTTAATTGCGATAACGAACGAGACCTCGGCCCTTAAATAGCCCGACCCGCGTCTGCGGGCCGCTGGCTTCTTAGGGGGACTATCGGCTCAAGCCGATGGAAGTGCGCGGCAATAACAGGTCTGTGATGCCCTTAGATGTTCTGGGCCGCACGCGCGCTACACTGACAGGGCCAGCGAGTACATCACCTTGGCCGAGAGGCCCGGGTAATCTTGTTAAACCCTGTCGTGCTGGGGATAGAGCATTGCAATTATTGCTCTTCAACGAGGAATGCCTAGTAGGCACGAGTCATCAGCTCGTGCCGATTACGTCCCTGCCCTTTGTACACACCGCCCGTCGCTACTACCGATTGAATGGCTCGGTGAGGCCTTCGGACTGGCCCAGGGGGGTTGGAAACGACCCCCCAGGGCCGGAAAGTTGGTCAAACCCGGTCATTTAGAGGAAGTAAAAGTCGTAACAAGGTTTCCGTAGGTGAACCTGCGGAAGGATCATTACCGAGTGCGGCACCCTCCGGGGTGCCAACCTCCCACCCGTGTCTACCGTACCACGTTGCTTCGGCGGGCCCGCCCCCCTCAGCAAGGGGGGGGCCGTCGGGGGGCATCTGCCCCCGGGCGTGTGCCCGCCGGAGACCCCCACACGAACACTGTCTGAAGGACTGCTGTCTGAGTGGATTGATCAAATCAGTTAAAACTTTCAACAACGGATCTCTTGGTTCCGGCATCGATGAAGAACGCAGCGAACTGCGATAAGTAGTGTGAATTGCAGAATTCAGTGAATCATCGAGTCTTTGAACGCACATTGCGCCCCCTGGCATTCCGGGGGGCATGCCTGTCCGAGCGTCATTGCTACCCTCAAGCACGGCTTGCGTGTTGGGCCGCCGTCCGCCCCGCTCCAGGGGGGGACGGGCCCGAAAGGCAGCGGCGGCACCGCGTCCGGTCCTCGAGCGTATGGGGCTCTGTCACCCGCTCCGTGGGGTCGGCCGGCGCTAGCCTGGGCAACCATCTTCTTTTTACCAGGTTGACCTCGGATCAGGTAGGGATACCCGCTGAACTTAAGCATATCAATAAGCGGAGGAAAAGAAACCAACCGGGATTGCCTCAGTAACGGCGAGTGAAGCGGCAAGAGCTCAAATTTGAAATCTGGCCCCCTCGGGGTCCGAGTTGTAATTTGTAGAGGATGCTTCGGGTGCGGCCCCTGTCGAAGTGNCCTGGAACGGGCCGTCNGAGAGGGTGAGANTCCCGTCTGGGATGGGGTGCCCGCGCCCGNGTGAAGCTCCCTCGACGAGT >UAMH10961_JN121732_Tsr1 ACCAGCCCGTGGGAAACATCAGAGGACCGCCCCCACGAGCCTGAAGACTGGCGCCGACTGCTTCAATTCGCCGACTACAAAGGCTCCAAGAATAAGGCTATCCGAGAAGCGCTGGTAGGCGGTGCCCACCCTGGCATCCGTATTGCTGTCCACCTTCGGGGAGTGCCATCGCGACTCCGCAATCGCCCGCAACCAGTGTCCTTGTTCTCCCTTCTTCGACACGAGCACAAATACACCGTTGTCAATATAAACATGAACTTGAACTCCGATTTCGAGGCGCCACTAAAGTCCAAAGAGGAACTCGTCATCCAATGCGGCCCACGGCGACTCGTCGTGAACCCCATCTTCTCTGCTGGCGGCGTCACTCCAAACAACGTCCACAAATTCGACCGATTCCTCCACCCCGGCCGCACCGCCATCGCCAGCTGGATCGGCCCGATGACATGGGGATCGGTACCGGTTCTCGTATTCAAAAACAAGCAAGTGCAGGACCCGGAAGTCCTCGACGCGTCTGACGAGACACCGACCATCAACCGTCTTGAACTCATCGGGACCGGCACCGTCGTCGCCCCTGACCAGTCCCGCGTTGTTGCCAAGCGTGCCATC |
IMAGES: